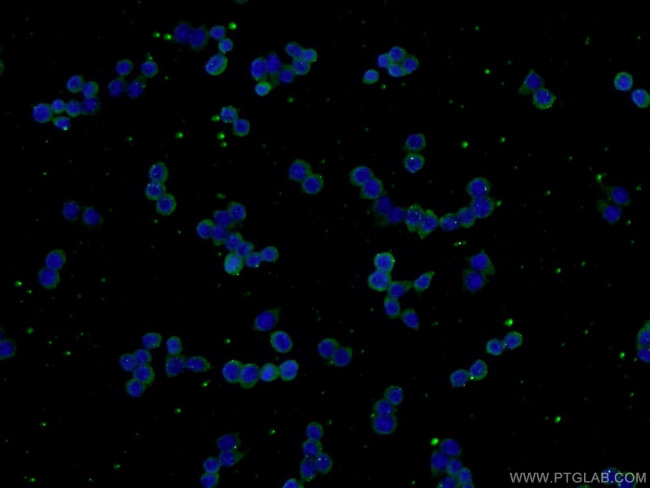
VEGFC Antibody in Immunocytochemistry (ICC/IF)
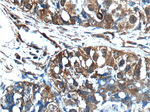
VEGFC Antibody in Immunohistochemistry (Paraffin) (IHC (P))

Search
Proteintech
VEGFC Polyclonal Antibody
{{$productOrderCtrl.translations['antibody.pdp.commerceCard.promotion.promotions']}}
{{$productOrderCtrl.translations['antibody.pdp.commerceCard.promotion.viewpromo']}}
{{$productOrderCtrl.translations['antibody.pdp.commerceCard.promotion.promocode']}}: {{promo.promoCode}} {{promo.promoTitle}} {{promo.promoDescription}}. {{$productOrderCtrl.translations['antibody.pdp.commerceCard.promotion.learnmore']}}
产品信息
22601-1-AP
种属反应
已发表种属
宿主/亚型
分类
类型
抗原
偶联物
形式
浓度
规格
纯化类型
保存液
内含物
保存条件
运输条件
产品详细信息
Immunogen sequence: SYLSKTLFE ITVPLSQGPK PVTISFANHT SCRCMSKLDV YRQVHSIIRR S (179-228 aa encoded by BC035212)
靶标信息
The protein encoded by this gene is a member of the platelet-derived growth factor/vascular endothelial growth factor (PDGF/VEGF) family, is active in angiogenesis and endothelial cell growth, and can also affect the permeability of blood vessels. This secreted protein undergoes a complex proteolytic maturation, generating multiple processed forms which bind and activate VEGFR-3 receptors. Only the fully processed form can bind and activate VEGFR-2 receptors. This protein is structurally and functionally similar to vascular endothelial growth factor D.
仅用于科研。不用于诊断过程。未经明确授权不得转售。
生物信息学
蛋白别名: Flt4 ligand; FLT4 ligand DHM; Flt4-L; unnamed protein product; Vascular endothelial growth factor C; vascular endothelial growth factor C isoform 129; vascular endothelial growth factor C isoform 184; Vascular endothelial growth factor-related protein; VEGF-C; VEGF3; VEGFC; VRP
基因别名: AW228853; Flt4-L; LMPH1D; LMPHM4; VEGF-C; VEGFC; VRP
UniProt ID: (Human) P49767, (Mouse) P97953
Entrez Gene ID: (Human) 7424, (Mouse) 22341